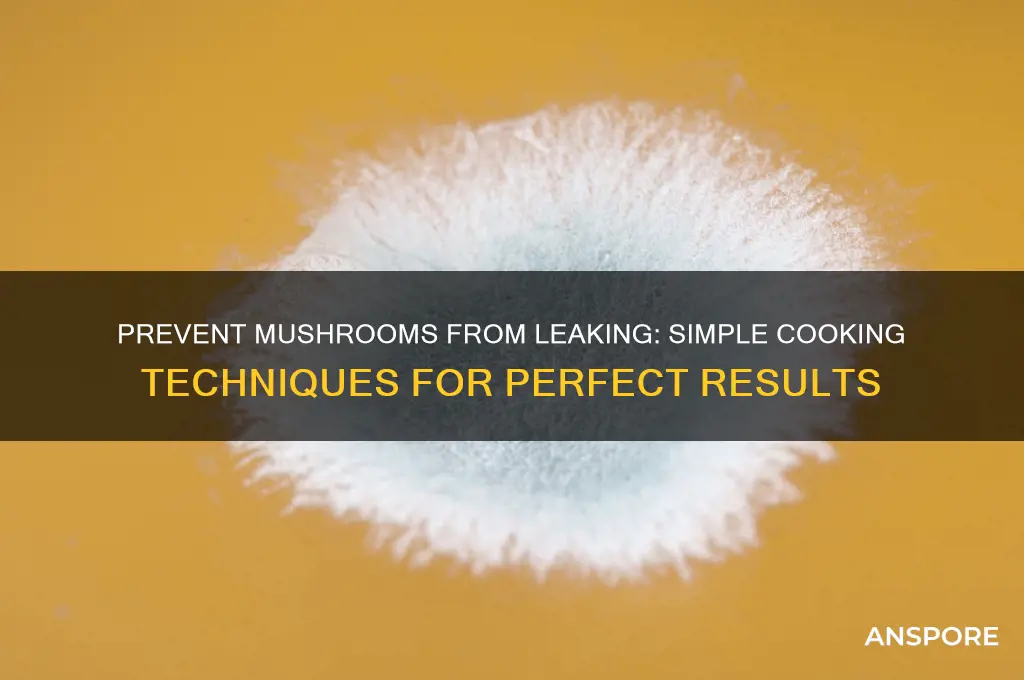
how to make mushrooms not leak

When preparing mushrooms for cooking, it's common to encounter the issue of them releasing excess moisture, which can affect the texture and outcome of your dish. To prevent mushrooms from leaking, start by selecting fresh, firm mushrooms and gently clean them with a damp cloth or brush instead of soaking them in water. Before cooking, pat them dry with a paper towel to remove any surface moisture. When sautéing, ensure the pan is hot and use a sufficient amount of oil or butter to create a barrier that helps seal in the moisture. Cook the mushrooms in a single layer, avoiding overcrowding, and resist the urge to stir them too frequently, allowing them to brown properly. Additionally, adding a pinch of salt toward the end of cooking can help draw out any remaining moisture without making them soggy. By following these steps, you can achieve perfectly cooked mushrooms that retain their flavor and texture without leaking excess liquid.
Explore related products
What You'll Learn
- Choose Fresh Mushrooms: Select firm, dry mushrooms with intact caps to minimize moisture release during cooking
- Pat Dry Thoroughly: Use paper towels to remove surface moisture before cooking for better searing
- Cook on High Heat: High heat evaporates moisture quickly, preventing soggy, leaky mushrooms
- Avoid Crowding the Pan: Give mushrooms space to cook evenly and release moisture without steaming
- Salt After Cooking: Salting mushrooms before cooking draws out moisture, causing leakage; salt at the end

Choose Fresh Mushrooms: Select firm, dry mushrooms with intact caps to minimize moisture release during cooking
The foundation of leak-free mushrooms lies in your grocery cart. Opt for mushrooms that feel like a firm handshake, not a soggy sponge. Look for caps that sit proudly atop their stems, free from cracks or tears. These visual cues signal a mushroom with minimal internal moisture, the primary culprit behind the dreaded "mushroom leak" during cooking.
Think of it like choosing a ripe peach – you want firmness, not softness.
This seemingly simple selection process has a profound impact on your culinary outcome. Mushrooms with compromised caps or a squishy texture have already begun to break down, releasing their internal juices. This moisture, when heated, turns into steam, causing your mushrooms to boil in their own liquid instead of achieving that desirable golden brown sear.
The result? A watery, flavorless mess instead of the rich, umami-packed mushrooms you crave.
Don't be afraid to get up close and personal with your mushrooms at the store. Give them a gentle squeeze – they should feel solid, not yielding. Inspect the caps for any signs of damage or discoloration. While a few small blemishes are acceptable, widespread bruising or tears are red flags. Remember, you're investing in the foundation of your dish, so choose wisely.
A little extra scrutiny at the grocery store translates to a world of difference on your plate.
Mastering Dual Extract Mushroom Powder: Simple Steps for Potent Results
You may want to see also

Pat Dry Thoroughly: Use paper towels to remove surface moisture before cooking for better searing
Moisture on mushroom surfaces can sabotage your quest for a golden sear. Before you even think about heat, grab a stack of paper towels. Gently press and pat each mushroom cap and stem, absorbing as much surface moisture as possible. This simple step is the foundation for achieving that coveted caramelized exterior.
Skipping this drying process leaves you with steamed, soggy mushrooms instead of the desired browning. The culprit? Water acts as a barrier, preventing direct contact between the mushroom and the hot pan, hindering the Maillard reaction responsible for those rich, savory flavors. Think of it as trying to tan through a wet towel – not very effective.
For best results, work in batches. Overcrowding the paper towels reduces their absorbency, leaving you with damp mushrooms. Aim for a single layer, allowing the towels to do their job efficiently. If you're dealing with particularly juicy mushrooms, consider using a clean kitchen towel as a second layer for extra absorption. Remember, the drier the surface, the better the sear.
This technique isn't just about aesthetics. A proper sear locks in juices, intensifying the mushroom's umami flavor. It also creates a textural contrast, with a crispy exterior giving way to a tender interior. So, before you reach for the pan, remember: a thorough pat dry is the secret weapon for mushroom perfection.
Perfectly Grilled Mushrooms and Onions: Easy Recipe for Flavorful Sides
You may want to see also

Cook on High Heat: High heat evaporates moisture quickly, preventing soggy, leaky mushrooms
High heat is the secret weapon in your quest to cook mushrooms that retain their texture and flavor without becoming watery. When mushrooms hit a hot pan, the intense temperature immediately begins to evaporate the moisture they naturally contain. This rapid evaporation process is key: it not only prevents the mushrooms from releasing excess liquid but also concentrates their earthy, umami-rich flavors. Think of it as a race against time—the quicker you can cook them, the less chance there is for them to turn soggy.
To execute this technique effectively, preheat your pan over medium-high to high heat for at least 2 minutes before adding oil or butter. Once the fat is shimmering (around 350°F to 375°F), add the mushrooms in a single layer, ensuring they have enough space to cook evenly. Overcrowding the pan will lower the temperature and cause steaming, which is the enemy of dry, browned mushrooms. Cook undisturbed for 2-3 minutes per side, allowing them to develop a golden-brown crust. This not only enhances flavor through the Maillard reaction but also seals in moisture, preventing leakage.
A common mistake is to stir mushrooms too frequently, which disrupts the browning process and encourages them to release liquid. Resist the urge to toss them around—let high heat do its job. If you notice liquid pooling in the pan, simply pour it off or use a spoon to remove it. This step is crucial, as excess moisture will reabsorb into the mushrooms if left unchecked. For larger batches, consider cooking in smaller portions to maintain consistent heat distribution.
The science behind this method is straightforward: high heat creates a dry environment that forces moisture out of the mushrooms before it can accumulate. This contrasts with low-heat cooking, which allows mushrooms to simmer in their own juices, resulting in a softer, leakier texture. By prioritizing speed and intensity, you’re not just cooking mushrooms—you’re transforming them into a concentrated, flavorful ingredient that holds its own in any dish. Master this technique, and you’ll never dread soggy mushrooms again.
Delicious Mushroom Pulao: Easy Recipe for Flavorful Rice Dish
You may want to see also
Explore related products

Avoid Crowding the Pan: Give mushrooms space to cook evenly and release moisture without steaming
Mushrooms are 90% water, and their cell walls release moisture rapidly when heated. Crowding the pan traps this moisture, turning your sauté into a soggy stew. Each mushroom needs breathing room to evaporate liquid efficiently, transforming it into a golden, crispy exterior while retaining interior juiciness. Think of it as a sauna versus a steam room: the former dries, the latter suffocates.
To achieve this, limit your pan occupancy. For a standard 12-inch skillet, cook no more than 8 ounces of mushrooms at once. Larger batches require multiple rounds. Preheat the pan over medium-high heat for 2 minutes before adding oil—this ensures immediate contact with heat, jumpstarting evaporation. Use 1 tablespoon of high-smoke-point oil (avocado or grapeseed) per batch to prevent sticking without creating a greasy barrier that traps moisture.
Stir minimally. Every toss releases trapped steam, but over-stirring cools the pan and prolongs cooking. Aim for 3–4 flips over 6–8 minutes. Listen for the sizzle: a consistent crackle indicates proper moisture release. If the sound dulls, reduce the quantity next time. For sliced mushrooms, spread them in a single layer; for whole ones, leave a mushroom’s width between each cap.
The payoff? Mushrooms with concentrated umami flavor, a texture that snaps under the teeth, and a pan fond (those browned bits) rich enough to deglaze into a sauce. Crowding sacrifices all this, yielding gray, rubbery specimens swimming in their own exuded liquid. Space isn’t just a courtesy—it’s the difference between a side dish and a centerpiece.
Crafting a Rich and Flavorful Mushroom Consommé: A Step-by-Step Guide
You may want to see also

Salt After Cooking: Salting mushrooms before cooking draws out moisture, causing leakage; salt at the end
Salting mushrooms before they hit the pan is a common mistake that leads to a soggy, watery mess. Mushrooms are like sponges, and salt acts as a magnet for their moisture. When you sprinkle salt on raw mushrooms, it draws out their natural juices through osmosis, leaving you with a pool of liquid in your pan and mushrooms that never achieve that desirable golden brown sear. This simple misstep can ruin the texture and flavor of your dish, turning what could be a savory, umami-packed ingredient into a limp afterthought.
To avoid this culinary pitfall, the solution is straightforward: salt your mushrooms after cooking. Start by heating a pan over medium-high heat and adding a tablespoon of oil or butter. Once the fat is hot, add your mushrooms in a single layer, ensuring they have enough space to cook evenly. Resist the urge to stir them immediately; let them sit undisturbed for 3-4 minutes to allow one side to develop a deep, caramelized crust. Flip the mushrooms and cook the other side for another 2-3 minutes. Only after they’ve achieved that beautiful sear should you season them with salt. This way, the salt enhances their flavor without compromising their texture.
The science behind this method is simple yet effective. By cooking the mushrooms first, you evaporate some of their natural moisture, concentrating their flavor. Adding salt at the end allows it to penetrate the mushrooms without drawing out additional liquid. This technique not only preserves their meaty texture but also ensures they remain tender and juicy inside. For best results, use kosher salt or sea salt, as their larger crystals provide better control over seasoning. Aim for about ¼ to ½ teaspoon of salt per pound of mushrooms, adjusting to taste.
This approach isn’t just about preventing leakage—it’s about maximizing flavor. Properly seared mushrooms develop a rich, nutty taste that pairs well with everything from pasta to steaks. By salting at the end, you maintain their structural integrity while amplifying their natural umami. It’s a small adjustment that makes a big difference, turning a potential kitchen mishap into a culinary triumph. So, the next time you cook mushrooms, remember: patience pays off, and the salt shaker waits until the very end.
Mushroom Power: Boosting Bowser's Health in Mario Maker Levels
You may want to see also
Frequently asked questions
Mushrooms leak because they contain high water content, and when heated, the moisture is released, causing them to become soggy and watery.
To prevent leaking, cook mushrooms over high heat in a single layer, avoid overcrowding the pan, and don’t add salt until the end, as salt draws out moisture.
Instead of washing, gently wipe mushrooms with a damp cloth or paper towel to remove dirt. Washing can add extra moisture, making them more likely to leak.
Yes, pre-cooking mushrooms in a dry pan over high heat until they release and evaporate their moisture can help prevent leaking when added to other dishes.
Yes, marinating mushrooms in liquid-heavy mixtures can increase their moisture content, leading to more leaking when cooked. Keep marinades light and pat mushrooms dry before cooking.

























